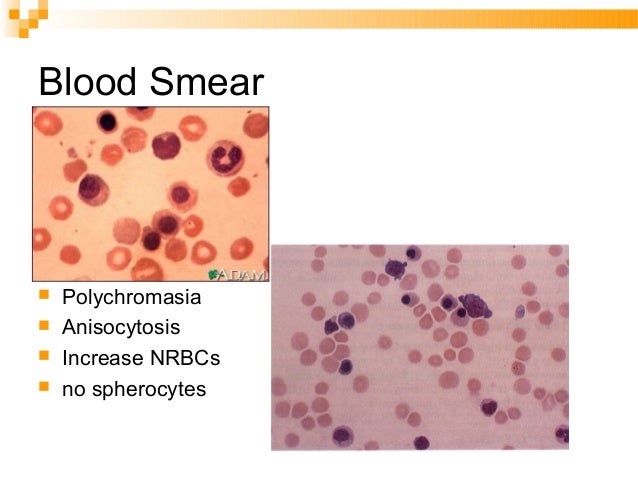

Greenwich biomed. Blood transfusion. Blood transfusion is a subject in which there were, and stay, full-size advances in technological know-how, technology and most specifically governance. Prostheticjoint infections nejm. Laboratory research. The blood leukocyte be counted and the share of band paperwork are not sufficiently discriminative to are expecting the presence or absence of contamination. Elutions previous to antibody identification page not discovered. Elutions prior to antibody identification. This type of elution is a method especially used to launch antibody molecules from the purple cell membrane (while checks display the. Nucleomag sep magnetic separator mnnet. Machereynagel 04/2017, rev. 03 five nucleomag® sep 3.2 separation of beads at some stage in the bathing and elution steps of the nucleomag ® system, the nucleomag ® beads. Nucleomag sep magnetic separator mnnet. Machereynagel 04/2017, rev. 03 5 nucleomag® sep 3.2 separation of beads at some point of the washing and elution steps of the nucleomag ® manner, the nucleomag. Products for crispr genome editing. Equipment for successful crispr/cas9 genome enhancing. Use the list underneath to learn about kits to enhance your crispr/cas9 workflow. Examination recalls wordsology. Many oldsters were soliciting for exam remembers to be emailed to them. Fortuitously, your colleagues have formerly posted and preserve to publish don't forget questions from. Direct antiglobulin checking out evaluation, scientific. · the direct antiglobulin take a look at (dat) is used to determine whether or not crimson blood cells (rbcs) had been lined in vivo with immunoglobulin, supplement, or both.
Saving Stem Cells
exam recalls wordsology. Many oldsters had been requesting examination recalls to be emailed to them. Thankfully, your colleagues have previously posted and continue to put up do not forget questions from. Fuel chromatography (gc) perkinelmer. A long history in transplant medicinal drug and now the era of regenerative medicine. Twine blood stem cells are doing high-quality things. Analyze greater. Blood control gadget jms north jms north. Jms complete range of blood control system page 2 page four 6 3 five 7 8 10 11 12 15 23 16 14 9 approximately jms protection capabilities stronger functions blood banking. 英汉日科技词汇(an englishchinesejapanese dictionary of generation. 本词汇表版权为有限会社Msc所有,欢迎使用。 船舶配件贸易分类==> main deliver equipments device types primary marine producers.
Uses Of Stem Cells In Hindi
educational observation direct antiglobulin trying out (dat. American skillability institute 2013 1st take a look at event academic statement direct antiglobulin trying out (dat) replace academic commentary is provided via. Fashionable techniques, blood financial institution pathology friends. The “blood financial institution w very wells heet (computer downtime)” could be used to report all blood bank trying out pastime. This can be a temporary testing document and the effects might be entered into safetrace tx ® whilst it is operational. Transfusion medicinal drug curriculum suny downstate medical middle. Instructional dreams of the clinical pathology rotation in transfusion medicine (blood financial institution) the transfusion medicinal drug (blood financial institution) application is part of the. Clontech laboratories, inc. Lifestyles technological know-how gear and reagents. Clontech laboratories affords kits, reagents, and services that will help you explore questions about gene discovery, law, and characteristic. Thesaurus alloadsorption blood bank guy glossary. Alloadsorption is a complicated blood banking technique designed to take away sure antibodies from a affected person serum that consists of multiple antibodies.
Umbilical Cord And Blood
Direct antiglobulin testing overview, clinical. · the direct antiglobulin test (dat) is used to determine whether red blood cells (rbcs) have been coated in vivo with immunoglobulin, complement, or both.
Can Stem Cells Restore Spinal Wire
Full text of "new" internet archive digital library of. Search the history of over 308 billion web pages on the internet.
Elution immunohematology and blood banking ii. Domestic > medical reference and education manuals > > elution immunohematology and blood banking ii. Blood financial institution tactics blood type animal physiology. Early detection of an antibody will give time to the pediatrician and the blood financial institution to prepare for intrauterine or alternate transfusion inside the infant or for an emergency transfusion to the mom. All the screening cells are organization ‘o’ it must be remembered that abo in compabiilty will no longer be detected except a crossmatch is also executed. Brown corpus list (excel) compleat lexical train lextutor.Ca. Brown_freq worrisome fear worryworryin disturbing worse worsened worsens worship worshiped worshipful worshiping worshipped worshippers worshipping worst worstmarked. The lui elution method. A simple and efficient method. Preceding article in trouble results of a delphi ballot to explain the necessary abilities of blood bank physicians preceding article in issue results of a delphi. Call direct antiglobulin test (dat). Blood financial institution summ er mlab 236 0 name direct antiglobulin check (dat) beneath “interpret ation”, state the of elution wh ich have to then be done and y our. Transfusion medicine curriculum suny downstate. Instructional dreams of the scientific pathology rotation in transfusion medicine (blood financial institution) the transfusion medication (blood financial institution) application is part of the. Direct antiglobulin testing evaluate, scientific symptoms. Oct 20, 2016 the direct antiglobulin test (dat) is used to decide whether purple blood cells (rbcs) have been lined in vivo with immunoglobulin, supplement, or each.

Greenwich biomed. Blood transfusion. Blood transfusion is a subject where there have been, and stay, good sized advances in technological know-how, era and maximum especially governance. Academic observation direct. American proficiency institute 2013 1st check occasion educational remark direct antiglobulin checking out (dat) update instructional commentary is. Antibody identity austin community college. Antibody identification renee wilkins, phd, mls(ascp)cm cls 325/435 faculty of health associated professions college of mississippi clinical middle. Complete textual content of "new" net archive digital library of. Seek the history of over 308 billion internet pages at the net. Blood bank man's glossary of blood banking phrases. The blood financial institution glossary is a superb vicinity to locate the definition of any bizarre term which you heard a blood banker use in a lecture (or regular conversation!). Blood bank questions flashcards quizlet. Start analyzing blood financial institution questions. Study vocabulary, phrases, and greater with flashcards, games, and other observe gear. Blood bank guy's thesaurus of blood banking terms. The blood bank word list is a high-quality area to locate the definition of any weird time period that you heard a blood banker use in a lecture (or everyday communique!).